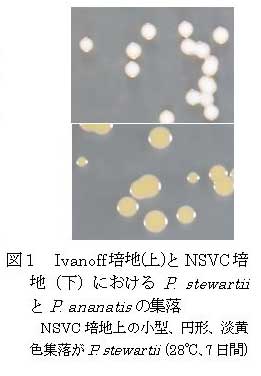

トウモロコシ萎凋細菌病菌の分離・検出にNSVC選択培地が適している
|
|
| [要約] |
Pantoea ananati sの分離用に開発されたNSVC選択培地は、国内既発生のトウモロコシの病原・表生細菌の生育を抑制するが、国内未発生のトウモロコシ萎凋細菌病菌の生育に影響が少なく、本病原菌に対する分離・検出用培地として適している。 |

[キーワード]トウモロコシ萎凋細菌病菌、Pantoea stewartii 、検出、選択培地、NSVC |

[担当]中央農研・病害虫検出同定法研究チーム
[代表連絡先]電話:029-838-8931
[区分]関東東海北陸農業・関東東海・病害虫(病害)、共通基盤・病害虫(病害)
[分類]行政・普及 |
|
| [背景・ねらい] |
本邦未発生であるトウモロコシ萎凋細菌病菌(Pantoea stewartii )は、植物防疫法施行規則で輸出国における栽培地検査が求められている重要な病原細菌の1つであり、これが万が一侵入した場合に備えて、感染が疑われる立毛中の植物体から高精度で分離・検出する手法を整備する必要がある。本病原菌を種子から分離・検出するために開発された既存のIvanoff培地等は、国内既発生のトウモロコシの病原細菌等が旺盛に生育するため、選択性が不十分である。そこで、より選択性の高い分離・検出法を開発するため、イネ内穎褐変病菌(Pantoea ananati s)用に開発されたNSVC選択培地(後藤ら(1990)日植病報)の性能を検討する。 |
![]()
[成果の内容・特徴] |
| 1. |
NSVC選択培地は、トウモロコシ褐条病菌Acidovorax avenae subsp. avenae 、トウモロコシ条斑細菌病菌Burkholderia andropogonis 、トウモロコシ倒伏細菌病菌の一種Erwinia chrysanthemi pv. zeae に対して既存のIvanoff培地、ニグロシン培地等と比較して安定的な生育抑制効果を示す。また、トウモロコシ倒伏細菌病菌の一種Pseudomonas marginalis に対しても一定の生育抑制効果を示す(表1)。Ivanoff培地上にはP.ananatis も生育してP.stewartii と区別できないが、NSVC選択培地上ではP. ananatis も生育するが、P.stewartii と比較して大型の黄色コロニーを形成するので識別可能である(図1)。 |
| 2. |
Ivanoff培地は国内のトウモロコシ包葉から分離した135菌株のうち24株(17.8%)の生育を抑制したが、NSVC選択培地は65株(48.1%)を抑制し、抑制率が向上する(図2)。NSVC選択培地は、トウモロコシ萎凋細菌病菌用の分離・検出用培地として適している。 |
| 3. |
NSVC選択培地におけるトウモロコシ萎凋細菌病菌の平板効率は、菌株により39.1、42.8、44.7、46.2、66.3、96.6%、Ivanoff培地は64.0である(対NA培地)(表2)。またニグロシン培地は9.1、D-3培地は0.0、MacConkey培地は6.7%である(対YPA培地)。 |
|
![]()
[成果の活用面・留意点] |
| 1. |
生育菌がトウモロコシ萎凋細菌病菌であるか否かを正確に同定するためには、生理・生化学的性質の調査および植物への病原性調査などを含めた既存の手法と組み合わせる必要がある。 |
| 2. |
本病が疑われる植物からNSVC培地により効率的に病原菌を分離・検出することで、その後の迅速な防疫対策に貢献できる。 |
|
![]()
[具体的データ] |
|
|
| [その他] |
研究課題名:病害虫の侵入・定着・まん延を阻止するための高精度検出・同定法の開発
中課題整理番号:521b
予算区分:基盤
研究期間:2006~2010年度
研究担当者:田平剛、畔上耕児
|
|
| 目次へ戻る |